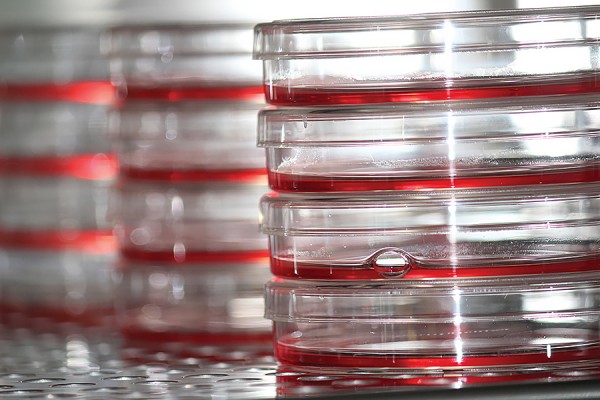

Two researchers from the Faculty of Science will discuss their current projects in a free public presentation Tuesday in Assumption Hall.
Dean Chris Houser, a professor of earth and environmental sciences, will give a lecture entitled “At the Water’s Edge: Saving lives in Costa Rica.”
Biology professor Lisa Porter will discuss “Stem Cells and Cancer: Pulling the plug on the fountain of youth.”
The event is part of the Outstanding Scholars Speakers Series. It will begin at 7:30 p.m. February 7 in the Freed-Orman Commons. To RSVP, e-mail Scholars@uwindsor.ca.
Academic Area: